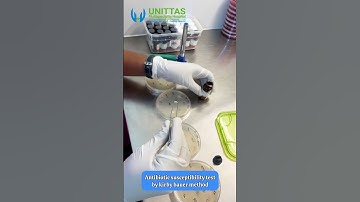
Kirby Bauer method for Antibiotic Susceptibility Testing | At Unittas Multispeciality Hospital

⬇ DOWNLOAD NOW
Kalau muncul iklan pop-up, tutup lalu klik tombol kembali
Download lagu The Inoculum Effect of Antibiotic Susceptibility Testing secara gratis hanya untuk keperluan promosi. Dukung artis favorit kamu dengan membeli musik original di iTunes atau platform resmi lainnya.
 Antibiotic Sensitivity testing
Antibiotic Sensitivity testing
 ID Laboratory Videos: Antibiotic susceptibility testing
ID Laboratory Videos: Antibiotic susceptibility testing
 1 Preparation of inoculum (english)
1 Preparation of inoculum (english)
 Kirby Bauer Disk Diffusion Method
Kirby Bauer Disk Diffusion Method
 Antibiotic sensitivity testing. 🧫
Antibiotic sensitivity testing. 🧫
Kirby Bauer method for Antibiotic Susceptibility Testing | At Unittas Multispeciality Hospital
Kirby Bauer method for Antibiotic Susceptibility Testing | At Unittas Multispeciality Hospital
 Streaking method for antibiotic susceptibility testing (AST) using swab technique. #Microbiology
Streaking method for antibiotic susceptibility testing (AST) using swab technique. #Microbiology
 Antibiotic Susceptibility testing
Antibiotic Susceptibility testing